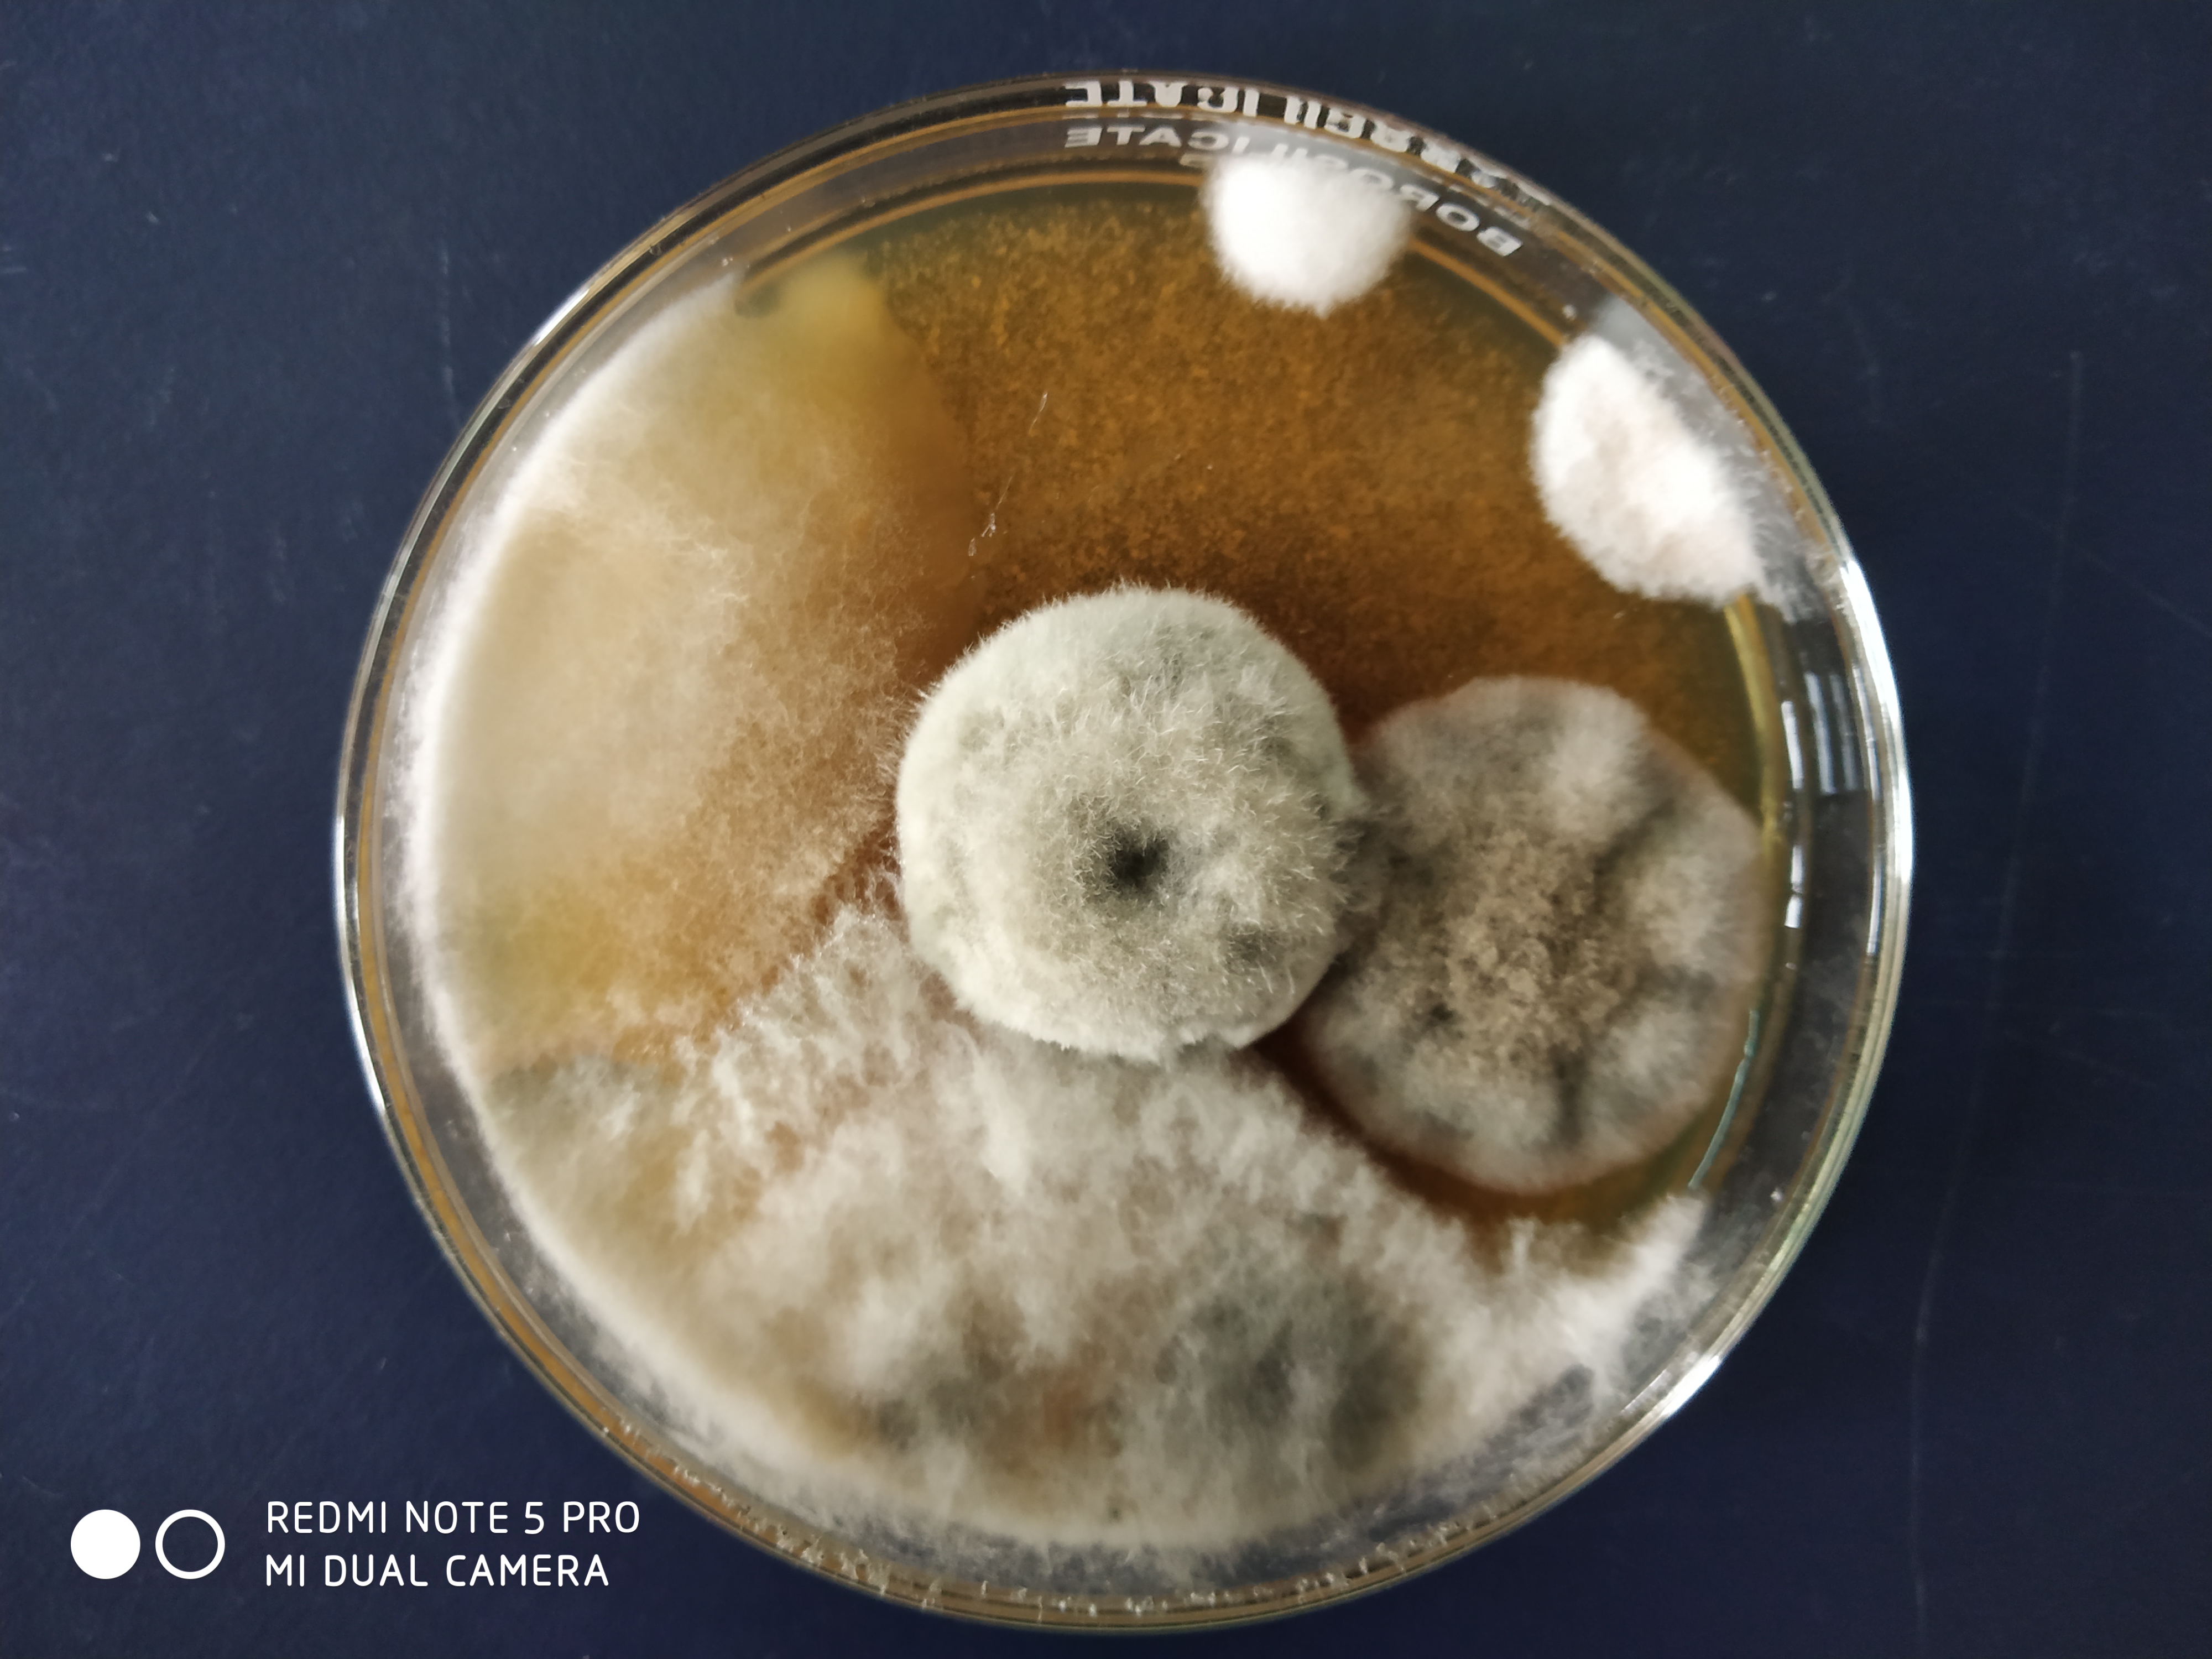
IMG_20180901_115321.jpg

Activity

Microorganisms

Unknown

Fungi & Lichen

Plants

Insects

Animals

Non Living

Information

Workshops

Lesson Plans
Mediashowing 12 of 25

Photo posted on Jan 19, 2026
image
Photo posted on Jan 19, 2026
image

Photo posted on Jan 19, 2026
image

Photo posted on Dec 23, 2025
image

Photo posted on Dec 23, 2025
image

Photo posted on Dec 23, 2025
image

Photo posted on Dec 23, 2025
image

Photo posted on Dec 23, 2025
image

Photo posted on Dec 23, 2025
image

Photo posted on Dec 23, 2025
image

Photo posted on Dec 23, 2025
image

Photo posted on Dec 23, 2025
image
More Posts from Prabhat Saikiashowing 11 of 11
Similar Foldscopers
A scientist at ICAR working on various aspects of environmental pollution and environmental toxicity
No post images available.
Dr. Pranay Punj Pankaj has got his training at BHU Varanasi, IIT Kanpur, IIT Kharagpur and NIMR (ICMR), New Delhi. He has qualified GATE with above 99 percentile and UGC-NET/JRF/SRF. He has been awarded by BHU Botanical Society, Varanasi for standing first in the essay writing competition, Mahavir Cancer Research institute, Patna for standing first in quiz competition in National Symposium (2010), International Society for Ecological Communications for Young Scientist Award (2009), ZSI for Young Scientist Award (2009) and M.S.E.T & I.C.C.B for Young Scientist Gold Medal Award (2010). He has also been awarded with prestigious Early Career Research (ECR) Award 2017 from DST-SERB, GoI. He is a fellow of Society of Applied Biotechnology, India (FSAB), Society of Life Sciences, Satna, India (FSLSc). He has published more than 20 research papers in national and international journals. Presently, he is an Assistant Professor at Nagaland University, Lumami, India.
No post images available.
No biography available.
No post images available.
I have completed my Ph.D from NERIST, Arunachal Pradesh. Interested in Ecology, Phenology, Microbiology and Medicinal plants.
No post images available.
Dr. Kalawati Saini did her graduation (1998) from M.S. College for women, Bikaner, M.D.S. University, M. Sc. (2000) and Ph.D. (2005) from Chemistry Department, University of Rajasthan, Jaipur. She received the IAAM Scientist Medal 2017 award by the International Association of Advanced Materials, USA for notable and outstanding research in the area of Advanced Materials Science & Technology. She was selected for Special Assistance Programme of UGC Research Fellowship and worked as Post-Doctoral Fellow in the Department of Physics, University of Rajasthan (2005-2006) and in the Materials Chemistry Lab, Department of Chemistry, I.I.T. Delhi (2007-2009). She is a dedicated teacher; her research interests include Materials Chemistry, Medicinal Chemistry, Electrochemistry and Crystallography. She is an expert in several analytical techniques such as powder XRD, single crystal XRD, TGA, Cyclic Voltammetry (CV), DCP, IR and UV/Visible spectroscopy. She has published several papers on her research work in peer-reviewed journals and presented her work in international/national conferences. She has a total of 12 years of experience of teaching Undergraduate and Post-Graduate classes. She has participated as Mentor and Facilitator at the summer workshops organised by D. S. Kothari Centre of Research and Innovation in Science Education, Miranda House. She was the Principal Investigator of the Innovation Project MH-204: "More miles on Yamuna" November, 2013- April, 2015; Completed (Funded by Research Council of University of Delhi) and another Innovation Project MH-310: "Sugarcane to Nanoparticles: Green Nanotechnology - the future" October 2015-16; Completed (Funded by Research Council of University of Delhi). She has been working in Miranda House, University of Delhi as Assistant Professor since 2009. She has been actively involved in College societies as a faculty advisor.
No post images available.
No biography available.
No post images available.
No biography available.
No post images available.
Associate Professor
Department of Botany and Forestry
Vidyasagar University
Midnapore
West Bengal
No post images available.
No biography available.
No post images available.
No biography available.
No post images available.

 Joined May 16, 2018
Joined May 16, 2018
 0 Applause
0 Applause 0 Comments
0 Comments














